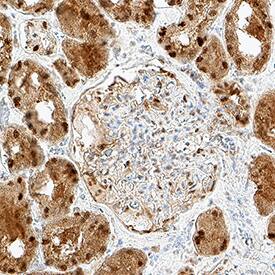

Human MTAP Antibody
R&D Systems, part of Bio-Techne | Catalog # MAB11747


Conjugate
Catalog #
Key Product Details
Species Reactivity
Human
Applications
Immunohistochemistry, Western Blot, Immunocytochemistry
Label
Unconjugated
Antibody Source
Monoclonal Mouse IgG2A Clone # 1113601
Product Specifications
Immunogen
E. coli-derived recombinant human MTAP
Accession # Q13126
Accession # Q13126
Specificity
Detects recombinant human MTAP protein in Direct ELISA
Clonality
Monoclonal
Host
Mouse
Isotype
IgG2A
Scientific Data Images for Human MTAP Antibody
Detection of Human MTAP by Western Blot.
Western Blot shows lysates of HT-29 human colon adenocarcinoma cell line, HCT-116 human colorectal carcinoma cell line and Raji human Burkitt's lymphoma cell line. PVDF membrane was probed with 1 µg/ml of Mouse Anti-Human MTAP Monoclonal Antibody (Catalog # MAB11747) followed by HRP-conjugated Anti-Mouse IgG Secondary Antibody (Catalog # HAF018). A specific band was detected for MTAP at approximately 29 kDa (as indicated). This experiment was conducted under reducing conditions and using Western Blot Buffer Group 1.Detection of MTAP in Human Colon.
MTAP was detected in immersion fixed paraffin-embedded sections of human colon using Mouse Anti-Human MTAP Monoclonal Antibody (Catalog # MAB11747) at 5 µg/ml overnight at 4 °C. Before incubation with the primary antibody, tissue was subjected to heat-induced epitope retrieval using VisUCyte Antigen Retrieval Reagent-Basic (Catalog # VCTS021). Tissue was stained using the HRP-conjugated Anti-Mouse IgG Secondary Antibody (Catalog # HAF007) and counterstained with hematoxylin (blue). Specific staining was localized to the cytoplasm and nucleus. View our protocol for Chromogenic IHC Staining of Paraffin-embedded Tissue Sections.Detection of MTAP in Human Kidney.
MTAP was detected in immersion fixed paraffin-embedded sections of human kidney using Mouse Anti-Human MTAP Monoclonal Antibody (Catalog # MAB11747) at 5 µg/ml overnight at 4 °C. Before incubation with the primary antibody, tissue was subjected to heat-induced epitope retrieval using VisUCyte Antigen Retrieval Reagent-Basic (Catalog # VCTS021). Tissue was stained using the HRP-conjugated Anti-Mouse IgG Secondary Antibody (Catalog # HAF007) and counterstained with hematoxylin (blue). Specific staining was localized to the cytoplasm and nucleus. View our protocol for Chromogenic IHC Staining of Paraffin-embedded Tissue Sections.Applications for Human MTAP Antibody
Application
Recommended Usage
Immunocytochemistry
3-25 µg/mL
Sample: Immersion fixed HT-29 human colon adenocarcinoma cell line and MCF-7 human breast cancer cell line
Sample: Immersion fixed HT-29 human colon adenocarcinoma cell line and MCF-7 human breast cancer cell line
Immunohistochemistry
3-25 µg/mL
Sample: Immersion fixed paraffin-embedded sections of human colon and human kidney
Sample: Immersion fixed paraffin-embedded sections of human colon and human kidney
Western Blot
1 µg/mL
Sample: HT-29 human colon adenocarcinoma cell line, HCT-116 human colorectal carcinoma cell line and Raji human Burkitt's lymphoma cell line
Sample: HT-29 human colon adenocarcinoma cell line, HCT-116 human colorectal carcinoma cell line and Raji human Burkitt's lymphoma cell line
Formulation, Preparation, and Storage
Purification
Protein A or G purified from hybridoma culture supernatant
Reconstitution
Reconstitute lyophilized material at 0.2 mg/ml in sterile PBS. For liquid material, refer to CoA for concentration.
Formulation
Lyophilized from a 0.2 μm filtered solution in PBS with Trehalose.
Shipping
Lyophilized product is shipped at ambient temperature. Liquid small pack size (-SP) is shipped with polar packs. Upon receipt, store immediately at the temperature recommended below.
Stability & Storage
Use a manual defrost freezer and avoid repeated freeze-thaw cycles.
- 12 months from date of receipt, -20 to -70 °C as supplied.
- 1 month, 2 to 8 °C under sterile conditions after reconstitution.
- 6 months, -20 to -70 °C under sterile conditions after reconstitution.
Background: MTAP
References
- Appleby, T.C. et al. (1999) Structure 7:629.
- Garbers, D.L. (1978) Biochim. Biophys. Acta. 523:82.
- Li, Y. et al. (2019) J. Cancer 10:927.
- Hellerbrand, C. et al. (2006) Carcinogenesis 27:64.
- Cairns, P. et al. (1995) Nat. Genet. 11:210.
- Christopher, S.A. (2002) Cancer Res. 62:6639.
- Kirovski, G. et al. (2011) Am. J. Pathol. 178:1145.
- Czech, B. et al. (2013) PLoS One 8:e80703.
- Henrich, F.C. et al. (2016) Oncoimmunology 5:e1184802.
- Kadariya, Y. et al. (2009) Cancer Res. 69:5961.
- Tang, B. et al. (2014) G3 (Bethesda) 5:35.
- Xu, J. et al. (2019) Signal Transduct. Target Ther. 4:2.
- Bertino, J.R. et al. (2011) Cancer Biol. Ther. 11:627.
- Tang, B. et al. (2018) Cancer Res. 78:4386.
- Bistulfi, G. et al. (2016) Oncotarget 7:14380.
Long Name
5'-Methylthioadenosine Phosphorylase
Alternate Names
BDMF, C86fus, DMSFH, DMSMFH, HEL-249, LGMBF, MTAPase
Gene Symbol
MTAP
UniProt
Additional MTAP Products
Product Documents for Human MTAP Antibody
Product Specific Notices for Human MTAP Antibody
For research use only
Loading...
Loading...
Loading...
Loading...